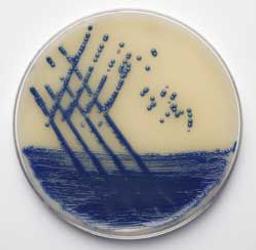

Brilliance MRSA AGAR
Brilliance™ MRSA is a new and improved chromogenic screening plate for MRSA. The medium combines excellent sensitivity with the simplicity of a chromogenic plate to create an invaluable tool in the implementation of infection control policy. Technique Brilliance MRSA Agar can be inoculated from screening swabs taken from hospital patients or staff, an isolated colony or from liquid suspension, according to local guidelines. T…

The supplier does not provide quotations for this product through SelectScience. You can search for similar products in our Product Directory.
We obteined great resuslts, I recommend it. We will buy it again in the near future.
Molecular entomology
We obteined great resuslts, I recommend it. We will buy it again in the near future.
Review Date: 21 May 2021 | Thermo Fisher Scientific
Very simple to use.
Bacteria culture
The product was of high quality, simple to use and specific. It is also a reliable product and it can be used for isolating Methicillin-Resistant Staphylococcus Aureus from clinical samples.
Review Date: 29 Jul 2016 | Thermo Fisher Scientific
Very good medium to grow bacteria! Very easy to USE! Cannot live without IT!
Cultivating bacteria
Very reproducible results. This medium is optimal for growing MRSA bacteria. It is the best I have tried.
Review Date: 11 Jul 2016 | Thermo Fisher Scientific
Good product!
Microbiology
Good product. Fast and reliable. Can be used directly from clinical material.
Review Date: 23 Jun 2016 | Thermo Fisher Scientific
Brilliance™ MRSA is a new and improved chromogenic screening plate for MRSA. The medium combines excellent sensitivity with the simplicity of a chromogenic plate to create an invaluable tool in the implementation of infection control policy.
Technique
Brilliance MRSA Agar can be inoculated from screening swabs taken from hospital patients or staff, an isolated colony or from liquid suspension, according to local guidelines. The medium should be allowed to warm to room temperature before inoculation. Incubate for 18-20 hours at 37ºC. There is no need to incubate beyond 24 hours. Denim blue colonies are presumptive positive for MRSA. Identifications as S. aureus can be confirmed with Staphytect Plus (DR0850) or Dryspot Staphytect Plus (DR0100), and PBP2′ (DR0900) can be used to confirm MRSA.
For further instructions on the use and interpretation of Brilliance MRSA Agar, simply download the data sheet (733KB) in PDF format.
Storage conditions and shelf life
Brilliance MRSA Agar plates should be stored in the original packaging at the temperature stated on the pack or product specification, and protected from direct light. When stored as directed, the unopened product will remain stable until the expiry date on the label.
Appearance
Prepared medium: Pale, off-white, opaque gel medium in Petri dishes.
A Comparative Evaluation of ChromID MRSA Agar and Brilliance MRSA 2 Agar for Detection of MRSA in Clinical Samples
This application note demonstrates a study to evaluate the performance of Brilliance MRSA 2 Agar compared to ChromID MRSA Agar.